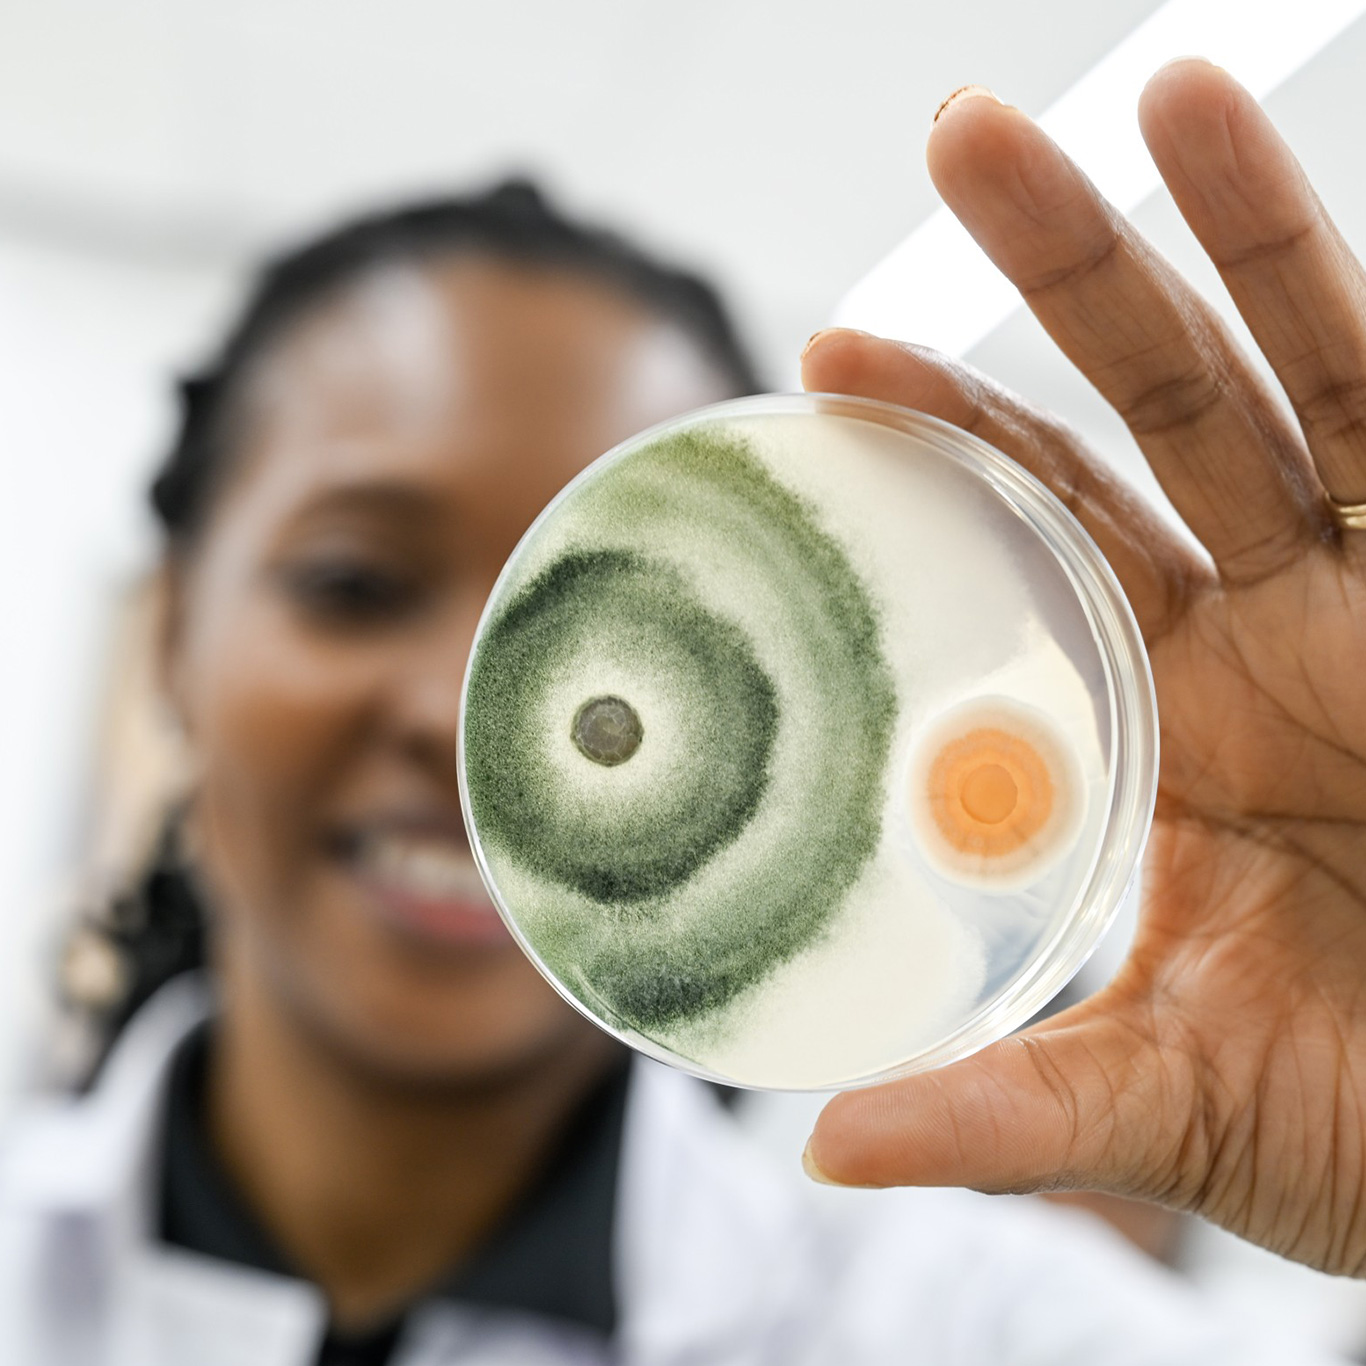

ال FS4Africa Open Call 1 provides a significant opportunity to research and technology stakeholders (start-ups, SMEs, research organisations and other multidisciplinary actors) to test, validate and enhance the business concepts and tools of the project or develop ideas and tools that contribute to project’s objectives which can then be introduced to the market.
- Implementation: March 2, 2026 - Feb 28, 2027
- Sub-projects: 10
- Total funding: 588k €